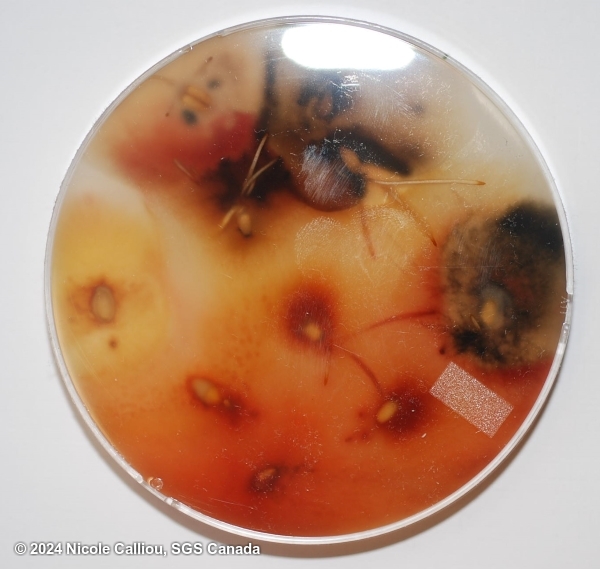
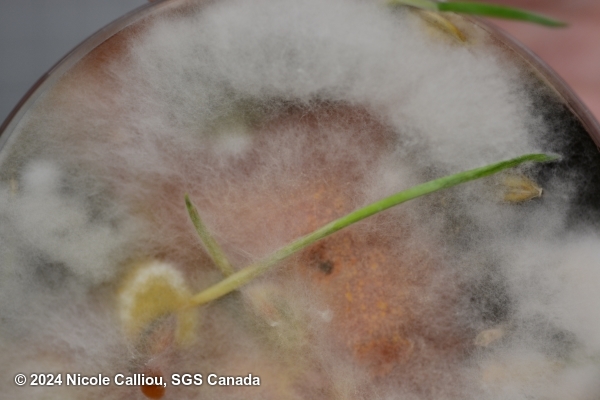

Submission
Fusarium culmorum on Triticum spp.
- Credits / Owner: Nicole Calliou, SGS Canada
- Submission date: 2024-06-28 19:54:01
- Submission ID: #62
Pathogen
|
Scientific name
|
Fusarium culmorum |
|
Genus
|
Fusarium |
|
EPPO code
|
FUSACU |
|
Common name
|
Cereal foot rot and head blight |
|
Synonyms
|
Fusisporium culmorum |
|
Crop
|
Triticum spp. |
Submission
Description
Typical fast growing Fusarium culmorum colony showing the orange coloration common on certain brands of PDA. Different brands can influence the coloration to be darker, almost red. Image 3 shows a close up of sporodochia which are also orange in color. Spores are commonly mistaken for F. crookwellense or F. sambucinum, but F. culmorum are usually 3-4 septate with a notched basal cell (no 'foot' shape), and the spores are very wide (often compared to maggots in our lab).
| Sterilant: | 1% NaOCl |
| Sterilant time: | 4 min |
| Growth time: | 5 days |
| Lighting: | 3:1 (fluorescent:nUV), within 60cm of light. Alternating light/dark in 12 hr intervals |
| Agar: | PDA |
| Agar brand: | Neogen |
| Sample origin: | Canada |